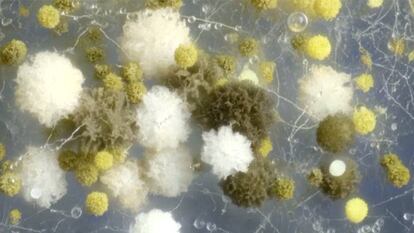

Esto es lo que ocurre en la naturaleza sin que nuestra vista lo capte
Un concurso elige las mejores grabaciones de hongos, larvas o protozoos
La larva de una estrella de mar buscando comida. Un ejército de ácaros dándose un festín en un irreconocible queso cheddar. O un agresivo protozoo en plena jornada de caza. Toda una serie infinita de acontecimientos naturales suceden ante nosotros sin que nuestra vista lo pueda captar, aunque sí los microscopios científicos.
Las mejores grabaciones científicas de este tipo han sido seleccionadas en el concurso Nikon Small World in Motion. El ganador de este año ha resultado el vídeo de la larva de estrella de mar, de William Gilpin (Universidad de Stanford). El segundo puesto ha sido para el cilio grabado por Charles Krebs y el tercero para el vídeo del crecimiento de un hongo contaminante de la comida, de Wim van Egmond. Otros vídeos tan excepcionales como los anteriores han recibido menciones honoríficas del jurado.


























































